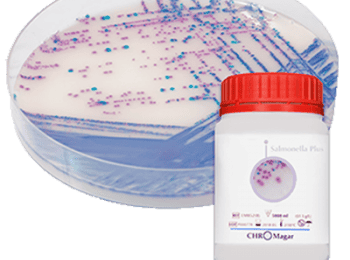
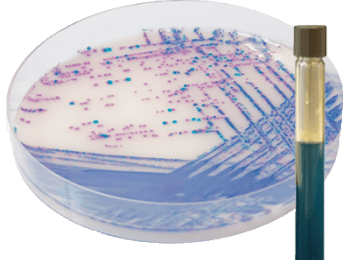

Medios de cultivo para salmonella - Serco Comercial
-
Disponibilidad de Medios de cultivo para salmonella - Serco Comercial:En stock
-
Unidad de Medios de cultivo para salmonella - Serco Comercial:Piezas
Descripción de Medios de cultivo para salmonella - Serco Comercial:
En Serco Comercial tenemos a tu disposición Medios de Cultivo para Salmonella. Nuestros productos se distinguen por su calidad y funcionalidad, son fáciles de usar, reducen el tiempo de pruebas, son confiables, se pueden trasladar al sitio de muestreo y su desecho es sencillo. Contáctanos aquí para mayor información.
En Serco Comercial tenemos a tu disposición Medios de Cultivo para Salmonella. Nuestros productos se distinguen por su calidad y funcionalidad, son fáciles de usar, reducen el tiempo de pruebas, son confiables, se pueden trasladar al sitio de muestreo y su desecho es sencillo. Contáctanos aquí para mayor información.


-
Cobertura de Medios de cultivo para salmonella - Serco Comercial Nacional
-
De Medios de cultivo para salmonella - Serco Comercial somos Distribuidor
4.8
Gabriela Ramirez Jimenez
3 años atrás
robert chavolla
8 años atrás
ale kim
8 años atrás
GABRIEL MENDOZA
7 años atrás
¡Atención! Las opiniones expuestas se toman de las que los usuarios escribieron en el registro de Google de esta empresa. No son directamente de nuestra plataforma en Cosmos. Te sugerimos validar tú mismo esta información.
RambaQUICK Salmonella de Medios de cultivo para salmonella - Serco Comercial
Medio de Cultivo para Salmonella cromogénico CHROMagar para la rápida detección de especies de Salmonella incluídas S. Typhi, S. Paratyphi y lactosa positiva.
CHROMagar Salmonella Plus de Medios de cultivo para salmonella - Serco Comercial
Medio de cultivo cromogénico CHROMagar para la detección y aislado de Salmonella, la detección también incluye si es lactosa + o -.
Aplicaciones de Medios de cultivo para salmonella - Serco Comercial
Los Medios de Cultivo para Salmonella que ofrecemos pueden ser utilizados en la industria alimentaria, de las bebidas, farmacéutica, bacteriología clínica, microbiología industrial, pruebas de agua y monitoreo ambiental.
Nuestro servicio de Medios de cultivo para salmonella - Serco Comercial
Comercializamos los más avanzados sistemas en higiene y microbiología rápida. Brindamos asesoría en la selección de los Medios de Cultivo para Salmonella más adecuados para cada cliente. Contamos con servicios de laboratorio y capacitación.
Agar Rambach de Medios de cultivo para salmonella - Serco Comercial
Medio de cultivo cromogénico CHROMagar para detectar y aislar Salmonella SPP en muestras de alimentos.


-
Cobertura de Medios de cultivo para salmonella - Serco Comercial Nacional
-
De Medios de cultivo para salmonella - Serco Comercial somos Distribuidor
4.8
Gabriela Ramirez Jimenez
3 años atrás
robert chavolla
8 años atrás
ale kim
8 años atrás
GABRIEL MENDOZA
7 años atrás
¡Atención! Las opiniones expuestas se toman de las que los usuarios escribieron en el registro de Google de esta empresa. No son directamente de nuestra plataforma en Cosmos. Te sugerimos validar tú mismo esta información.
Otros productos que vende Serco Comercial

$ 22,700 MXN
Min. Caja con 100




$ 22,700 MXN
Min. Caja con 100



¿Necesitas una cotización personalizada?
Nuestro equipo técnico puede ayudarte a seleccionar Medios de cultivo para salmonella - Serco Comercial ideal según tu línea de producción, velocidad y tipo de material.